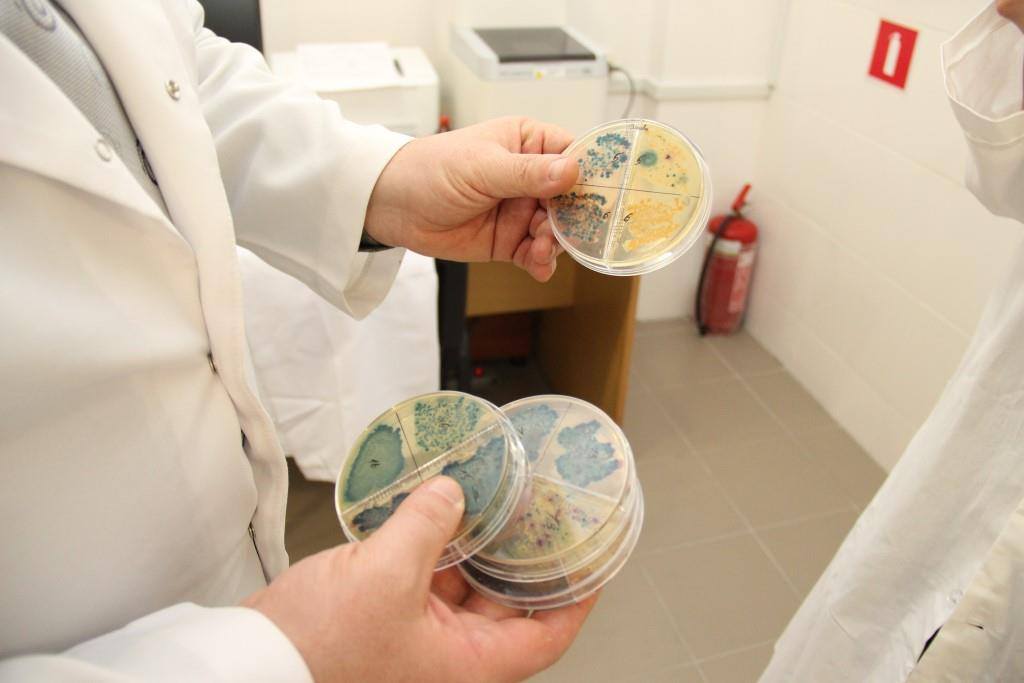
nov 15 12 2017 abm 2

Урочисто перерізали символічну стрічку - голова Всеукраїнської Аграрної Ради Андрій Дикун, заступник директора Департаменту тваринництва Олена Альшанова та заступнику директора офісу економічного зростання, місії USAID в Україні Стівен Ринецкі. Із вітальним словом також виступив Дуайт Вайлдер, аграрний атташе Посольства США в Україні.
«Було дуже важливим знайти ініціаторів цього проекту, тих хто готовий «проштовхувати» свою ідею. Коли я побачив перспективи молочного сектору України, то зрозумів можливості нашої співпраці. Ми надзвичайно горді тим, що тут відкрили лабораторію, адже співпраця виробників молока та уряду США ― це дуже важливо. Такий підхід, де приватний сектор виступає драйвером, потрібен всюди», - підкреслив Стівен Ринецкі.

Під час офіційної частини виступили віце-президент АВМ Ганна Лавренюк, котра розповіла про мотиви та історію створення Лабораторії і співпраці асоціації із USAID, наголосила на законодавчих змінах, які вимагатимуть нового рівня відповідальності від молочнотоварних ферм (новий Наказ про гігієну молока та відновлення державних перевірок операторів ринку згідно ЗУ № 2042 «Про державний контроль…»), зауважила на глобальній проблемі раціонального використання антибіотиків для зменшення розвитку резистентності бактерій та ролі виробників молока у цьому процесі.
Директор Лабораторії якості молока Андрій Білан розповів про кращий світовий досвід контролю якості молока, який імплементовано у Лабораторії АВМ, детально розібрав економічні та соціальні збитки від маститу – ключової хвороби високопродуктивних стад. Лабораторія АВМ здійснює аналізи молока на фізико-хімічні показники, а також оперативні (2-3 дні від моменту отримання зразка) мікробіологічні дослідження молока, виділень, змивів із доїльного обладнання тощо на ідентифікацію збудників (найперше маститу!) та визначення їх чутливості до антибіотиків. А. Білан продемонстрував відео-тур лабораторією із детальним покроковим «маршрутом» зразка молока від ферми до отримання та інтерпретації результатів.

Також, у заході взяли участь представники компаній-партнерів АВМ, які надали обладнання для лабораторії, представники переробних підприємств та господарств, Олена Жупінас, керівник проекту АВМ «Гуртові закупівлі молока», Валерій Лотоцький, керівник розвитку департаменту ветеринарії Консультаційного Центру АВМ.
«Наразі на виробників молока покладена велика відповідальність та вимоги щодо виготовлення безпечного молока. Тому, Асоціація виробників молока пропонує вирішення проблем антибіотикорезистентності, економічних втрат та найперше маститів, за допомогою Лабораторії якості молока», - зазначає прес-служба АВМ.





